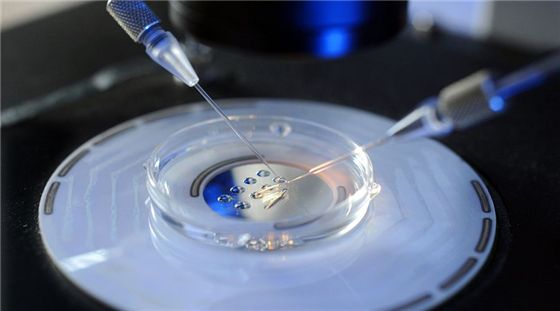
上海助孕中心官网

2025-10-27 11:26:58
|
| 上海基因检测多少钱一次?上海试管基因检测(PGT)费用一次约2至5万元! |
|
| 上海三代试管包生男孩价格(2025上海三代试管包生男孩价格清单最新) |
|
| 上海高龄试管成功案例(2025年上海高龄试管成功案例分享) |
|
| 上海试管婴儿双胞胎价格?2025在上海做试管生双胞胎约8至25万元! |
|
| 上海单身可做试管的医院(2025上海单身可做试管的医院优选10家) |
|
| 上海第三代试管包生男孩多少费用?2025上海三代试管医院包生男孩约6至10万元! |
